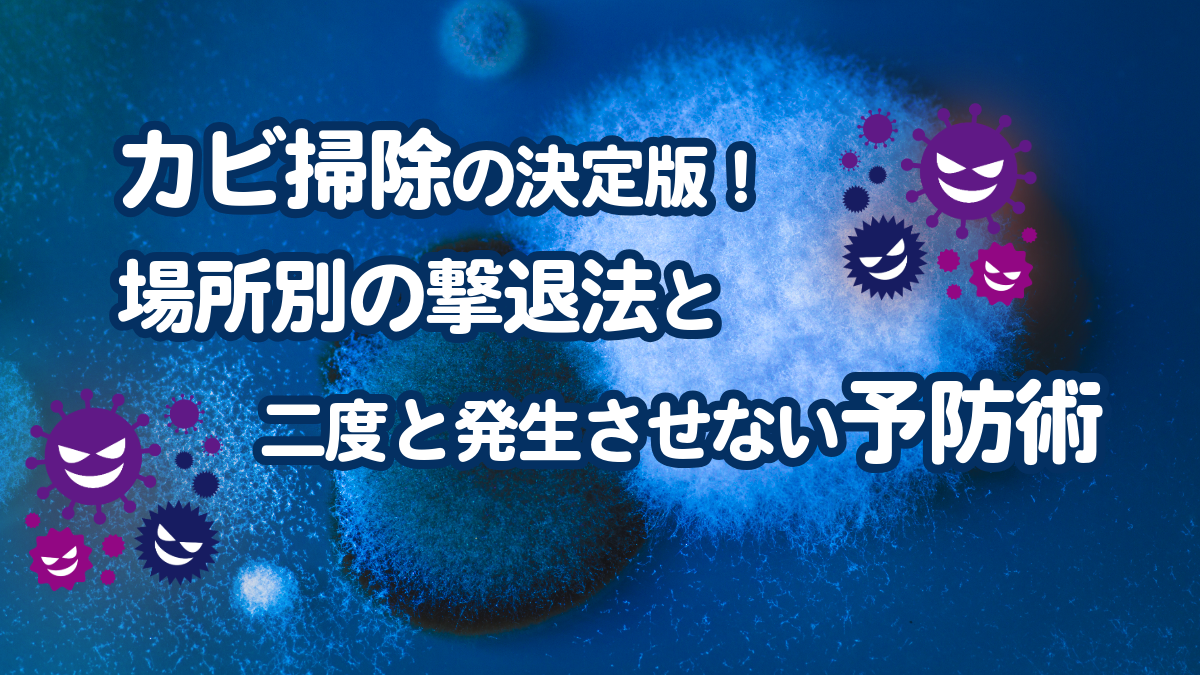

「掃除したはずなのに、また黒い点々が……」 家の中の頑固なカビに、頭を悩ませていませんか?
お風呂場のゴムパッキン、窓の結露部分、キッチンの排水溝。カビは見た目が悪いだけでなく、アレルギーや喘息の原因になるなど、ご家族の健康にも悪影響を及ぼす厄介な存在です。
実は、カビ掃除には「やってはいけないNG行動」と、プロが知っている「根こそぎ落とすコツ」があります。
今回は、家事代行のプロが実践している「正しいカビ掃除の方法」と、掃除後にカビを「二度と発生させないための予防テクニック」を徹底解説します。
この記事を読んで、カビとの長い戦いに終止符を打ちましょう。
そもそも、なぜカビは発生するのか?

敵を倒すには、まず敵を知ることから始めましょう。 カビが発生・増殖するためには、以下の3つの条件が必要です。
- 湿度(水分): 湿度が70%を超えるとカビ菌は活発になります。
- 温度: 人間が快適と感じる20〜30℃を好みます。
- 栄養分: ホコリ、皮脂汚れ、石鹸カス、食べこぼしなど。
日本の住宅、特に気密性の高いマンションなどは、一年中この条件が揃いやすくなっています。「水分」を断ち、「栄養」を与えないことが、カビ対策の基本戦略となります。
【場所別】プロが教える「カビ掃除」の正解

カビは発生した場所や素材によって、最適な洗剤や掃除方法が異なります。ここからは、場所別の具体的な掃除テクニックをご紹介します。
お風呂場(浴室)のカビ掃除
もっともカビ悩みが多い場所です。特にゴムパッキンの黒カビは「根」を深く張っているため、表面をこするだけでは落ちません。
用意するもの
塩素系漂白剤(カビキラーなど)、キッチンペーパー、ラップ
プロの技【湿布法(パック)】
- 水分を拭き取る
これが最も重要です。濡れていると薬剤が薄まり効果が半減します。必ず完全に乾いた状態にします。
- 薬剤を塗布し、ペーパーで覆う
カビ部分に漂白剤をかけ、その上からキッチンペーパーを貼り付けます。
- さらにラップをする
乾燥を防ぎ、薬剤を浸透させるためにラップで蓋をします。
- 放置して流す
30分〜1時間ほど放置した後、水でよく洗い流します。
注意: 酸性タイプの洗剤と混ぜると有毒ガスが発生するため、絶対に単独で使用してください。
窓・サッシ・壁紙のカビ掃除
窓周りの結露によるカビや、壁紙のカビには、色落ちのリスクがある塩素系漂白剤は使えません。「消毒用エタノール」が活躍します。
用意するもの
消毒用エタノール(ドラッグストアやホームセンターなどで購入可能)、乾いた雑巾
掃除の手順
- エタノールを吹きかける
いきなり拭くとカビの胞子を撒き散らしてしまいます。まずはエタノールで殺菌します。
- 優しく拭き取る
乾いた布で優しく拭き取ります。ゴシゴシこするのはNGです。
- 乾燥させる
最後にしっかり換気をして乾燥させます。
キッチン(排水溝・シンク)のカビ掃除
食品を扱う場所では、強力な洗剤を使いたくないという方も多いでしょう。エコ洗剤での掃除がおすすめです。
用意するもの
重曹、クエン酸、お湯(40〜50℃)
掃除の手順
- 重曹を振りかける
排水溝やカビが気になる部分にたっぷりと重曹をまきます。
- クエン酸水をかける
クエン酸をお湯で溶かしたものを上からかけます。
- 発泡洗浄
シュワシュワと泡立ちます。この泡が汚れを浮かせます。30分ほど放置して洗い流しましょう。
クローゼット・押入れのカビ掃除
空気が滞留しやすい収納内部のカビは、除菌と乾燥が鍵です。
用意するもの
消毒用エタノール、乾いた雑巾、扇風機やサーキュレーター
掃除の手順
- 中身をすべて出す
荷物を出し、カビが生えた衣類はクリーニングへ。
- エタノールで除菌
窓・壁紙同様、エタノールを含ませた布で拭き取ります。
- 扇風機で乾燥
掃除後は、扉を開け放ち、扇風機やサーキュレーターで風を送り込み、完全に湿気を飛ばします。
絶対にやってはいけない「NGカビ掃除」

良かれと思ってやっているその行動が、逆にカビを広げているかもしれません。
× 水拭きをする
カビにとって水分は栄養源です。また、濡れた雑巾で拭くことで胞子を塗り広げてしまいます。
× 掃除機で吸う
カビの胞子は非常に小さいため、掃除機の排気口から部屋中に撒き散らされてしまいます。フィルター内でカビが繁殖する原因にもなります。
× お酢を使う
クエン酸はOKですが、穀物酢などはアミノ酸などの成分が含まれており、カビの栄養分になってしまうことがあります。
カビを「発生させない」ための3つの鉄則
苦労して掃除をした後は、きれいな状態をキープしたいものです。「カビを発生させない」ためには、日々のちょっとした習慣が大切です。
「50℃シャワー」でカビの芽を殺す(お風呂場)
カビの菌糸は熱に弱く、50℃以上の熱湯を5秒間かけると死滅すると言われています。 週に1回程度、お風呂上がりに浴室全体(特に床や壁の下の方)に50℃のお湯をかけ、その後に冷水シャワーで浴室内の温度を下げてから出ると、カビ予防に劇的な効果があります。
「換気」を徹底し、空気の通り道を作る
湿気を溜めないことが最大の予防です。
- 24時間換気
浴室やトイレの換気扇は常につけっぱなしにしましょう。電気代は月に数百円程度です。
- 家具の配置
壁と家具の間を5cmほど空け、空気が流れるようにします。
- クローゼット
定期的に扉を開けたり、スノコを敷いて下に空気を通したりしましょう。
カビの「栄養源」を残さない
カビはホコリや石鹸カスを食べて育ちます。
- お風呂上がりには壁についた泡をしっかり流す。
- 部屋の隅のホコリをこまめに取り除く。
これだけで、カビのリスクは大幅に下がります。また、天井や手の届かない場所に使える「防カビくん煙剤」などの予防グッズを定期的に使用するのも賢い方法です。
根深いカビや広範囲の掃除はプロにお任せください
ここまで、カビ掃除の方法やカビ対策をご紹介しました。ご家庭でも簡単に実践できると思います。しかし、以下のような場合はプロの手を借りてみてください。
- 忙しくて、じっくり掃除をする時間が取れない
- アレルギー体質で、カビ掃除自体が健康リスクになる
- 定期的にカビ掃除や対策をしっかり行いたい
私たち家事代行サービスはご家庭にあるお掃除道具や洗剤でできる最大限のお掃除をいたします。
また、掃除だけでなく、「なぜそこにカビが生えたのか」という原因を突き止め、ご家庭の環境に合わせた「発生させないためのアドバイス」も行っています。
一度リセットすることで、日々のお手入れがぐんと楽になります。「カビを見ない生活」を取り戻すために、ぜひ一度プロの技をご体験ください。
まとめ
カビ掃除のポイントは「乾燥させてから薬剤を使うこと」、そして予防のポイントは「湿度コントロールと栄養除去」です。 正しい知識でカビに対処し、清潔で健康的な住まいを守りましょう。
もし手に負えないと感じたら、無理をせずいつでも私たちにご相談ください。
家事代行サービス『ぱぱっと!ママット』へのお問い合わせはコチラから。